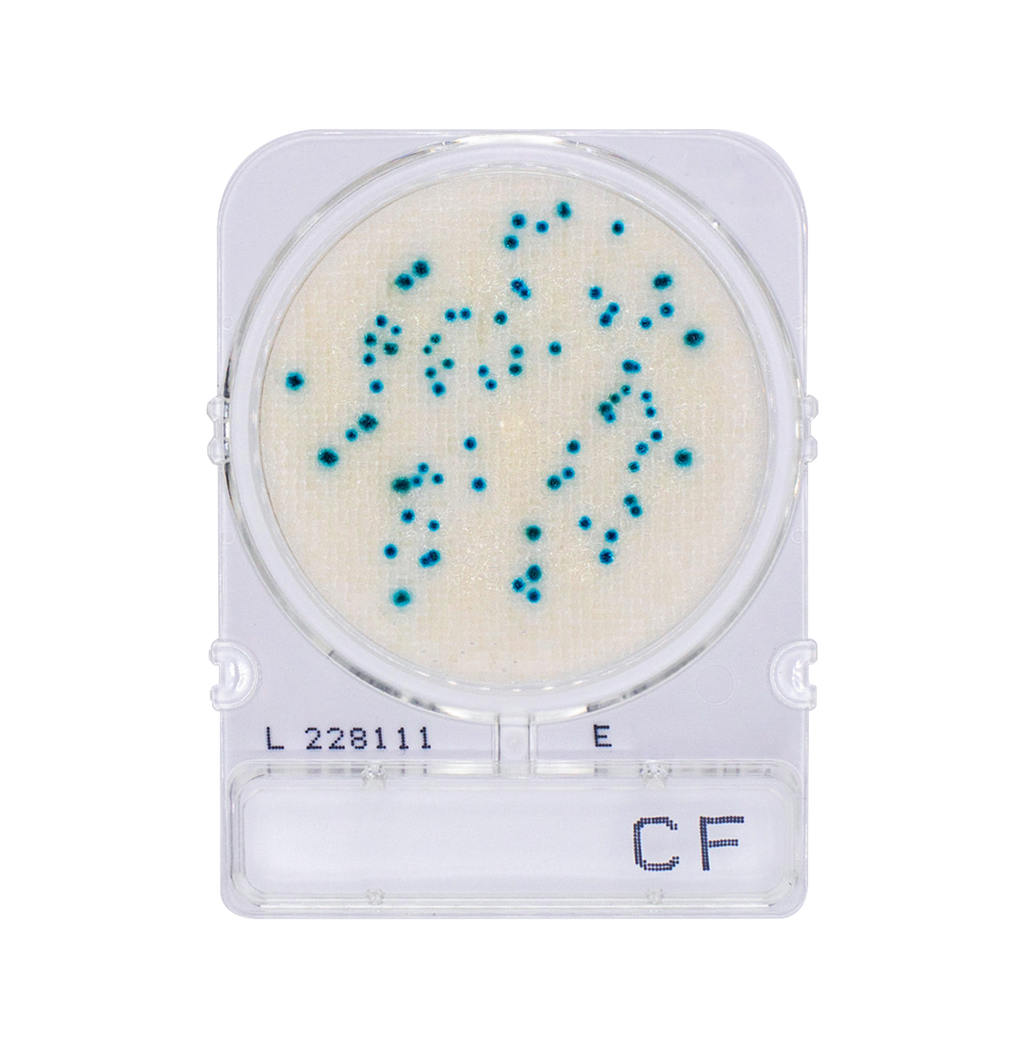
Compact Dry CF | Coliform

Join our community
Subscribe for expert insights and updates on food safety innovations.

Compact Dry CF plates provide a quick, reliable count of total coliforms. A chromogenic substrate tints coliform colonies blue to blue-green, while growth of non-target flora is largely suppressed and, if present, remains colorless—making enumeration effortless.
Safeguard product quality and comply with food-safety regulations by monitoring coliform levels at each critical control point.
Key Benefits
Incubation parameters
| Sample Type | Temperature | Time |
| Raw Meat | 35 ± 1 °C | 24 ± 2 h |
| Other matrices | 37 ± 1 °C | 24 ± 2 h |
Performance
Countable range: 1 – 300 CFU per plate (1 mL inoculum).
We will work quickly to ship your order from our Houston warehouse as soon as possible. Once your order has shipped, you will receive an email with further information. Delivery times vary depending on your location and shipping selection at checkout.
Our team of specialists are here to support you. Talk to a specialist and get a complimentary sample of Compact Dry plates!